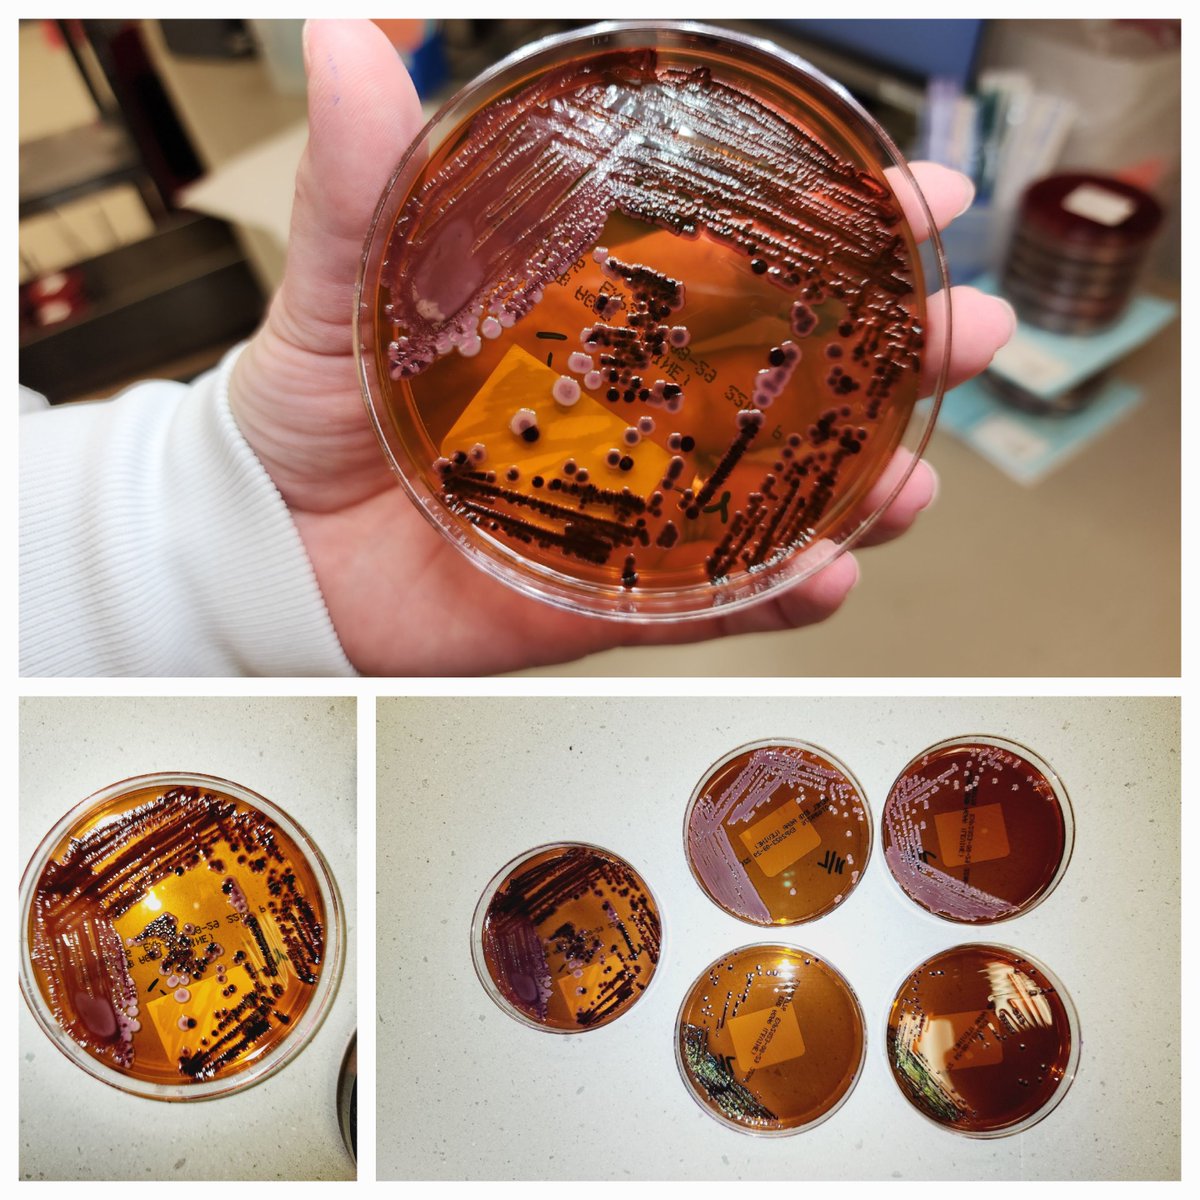
Saadiya Nazli, MD, BSc, QIA(ASCP) tweet media

Sabitlenmiş Tweet

Hi #PathTwitter
I am Priyanka Sachdev, a Canadian-Pakistani MD applying to #Pathology for this #PathMatch24. 🔬
I am passionate about surgical pathology and hematological malignancies!
I love reading, good food and good cup of coffee ☕️
#match2024 #pathology

English